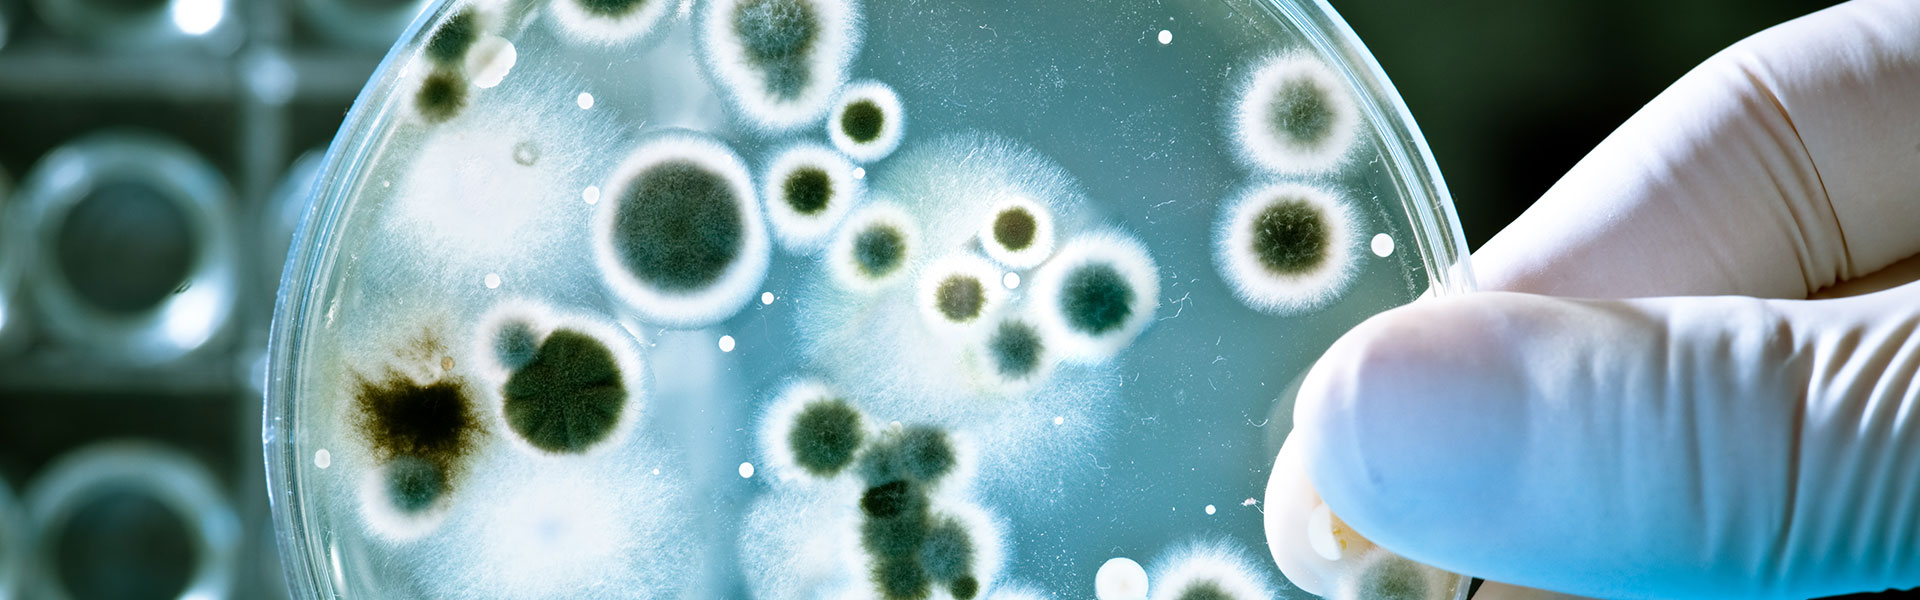

Πρόγραμμα PHIG 2016
Πρόγραμμα PHIG - Preventing Hospital Infections in Greece
Από τον Ιανουάριο του 2016, το CLEO επέκτεινε τη δράση του και σε άλλους τομείς έρευνας και προαγωγής της υγείας, με συνεργασίες σε όλη την Ελλάδα, σε νοσοκομεία Παίδων και Ενηλίκων. Σε αυτά τα πλαίσια σχεδιάστηκε το πρόγραμμα «Πρόληψη των Νοσοκομειακών Λοιμώξεων στην Ελλάδα - PHIG», σκοπός του οποίου ήταν η επιτήρηση των πιο συχνών νοσοκομειακών λοιμώξεων, της συμμόρφωσης σε επιλεγμένες πρακτικές πρόληψης και της χρήσης των αντιβιοτικών. Το πρόγραμμα υλοποιήθηκε μέσω δωρεάς του Ιδρύματος Σταύρος Νιάρχος, διήρκεσε συνολικά τέσσερα χρόνια και ολοκληρώθηκε τον Δεκέμβριο του 2019.
Η οργάνωση του προγράμματος βασίστηκε σε 6 διαφορετικούς άξονες:
- Υγιεινή των χεριών (Hand Hygiene - HH)
- Μικροβιαιμίες Σχετιζόμενες με Κεντρική Γραμμή (Central Line Associated Bloodstream Infections - CLABSI)
- Ουρολοιμώξεις Σχετιζόμενες με Ουροκαθετήρα (Catheter Associated Urinary Tract Infections - CAUTI)
- Επιπλοκές Σχετίζόμενες με Αναπνευστήρα (Ventilator Associated Events - VAE)
- Χρήση αντιμικροβιακών φαρμάκων
- Χρήση Περιεγχειρητικής Αντιμικροβιακής Προφύλαξης (Perioperative Antibiotic Prophylaxis - PAP)
Το πρόγραμμα χωρίστηκε σε τρεις διαδοχικές φάσεις:
1. Πιλοτική Φάση
Κατά τη διάρκεια της πιλοτικής φάσης υλοποιήθηκαν οι εξής δράσεις:
- Αναπροσαρμογή των εργαλείων συλλογής δεδομένων στις ιδιαίτερες ανάγκες και απαιτήσεις της εκάστοτε μονάδας.
- Εκπαίδευση ιατρονοσηλευτικού προσωπικού αναφορικά με την ορθή χρήση των εργαλείων συλλογής δεδομένων και εξοικείωσή του με την ορολογία που χρησιμοποιείται για την επιτήρηση και τον έλεγχο των λοιμώξεων.
2. Φάση Βασικής Επιτήρησης
Κατά τη διάρκεια της φάσης της βασικής επιτήρησης υλοποιήθηκαν οι εξής δράσεις:
- Αξιολόγηση των υλικοτεχνικών υποδομών για την υγιεινή των χεριών σε κάθε μονάδα.
- Επιτήρηση της συμμόρφωσης με τους κανόνες υγιεινής των χεριών.
- Επιτήρηση των περιστατικών CLABSI, CAUTI και VAE.
- Επιτήρηση της χρήσης των αντιμικροβιακών φαρμάκων.
- Επιτήρηση της PAP.
3. Φάση Παρεμβάσεων
Στην τρίτη και τελευταία φάση του προγράμματος υλοποιήθηκε ο σχεδιασμός και η εφαρμογή μιας δέσμης παρεμβάσεων προσαρμοσμένων στις ιδιαίτερες απαιτήσεις καθενός τμήματος ξεχωριστά. Κατά τη διάρκεια αυτής της φάσης συνεχίστηκε η επιτήρηση των επιλεγμένων νοσοκομειακών λοιμώξεων και της χρήσης των αντιβιοτικών.